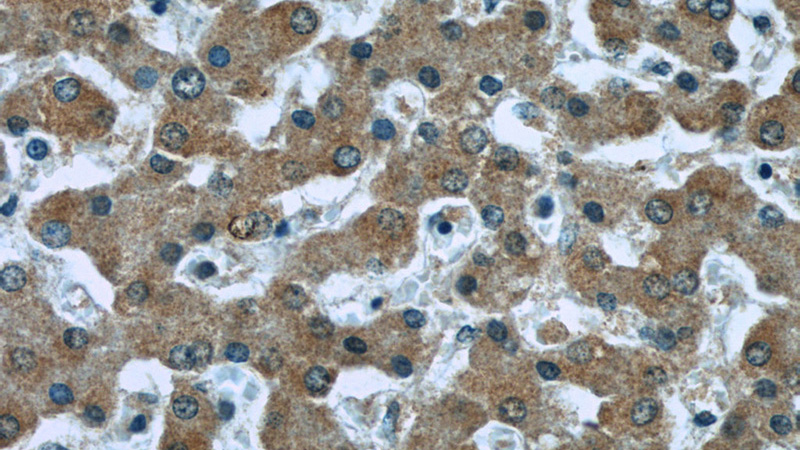
Immunohistochemistry of paraffin-embedded human liver slide using Catalog No:107033(CASP8 Antibody) at dilution of 1:50

-
Product Name
Caspase 8/p18 antibody
- Documents
-
Description
Caspase 8/p18 Mouse Monoclonal antibody. Positive WB detected in HeLa cells, HepG2 cells. Positive IP detected in HepG2 cells. Positive IHC detected in human liver tissue. Observed molecular weight by Western-blot: 60,50,45,18 kDa
-
Tested applications
ELISA, IHC, WB, IP
-
Species reactivity
Human; other species not tested.
-
Alternative names
Apoptotic cysteine protease antibody; Apoptotic protease Mch 5 antibody; Casp 8 antibody; CASP8 antibody; Caspase 8 antibody; Caspase 8/p18 antibody; Caspase8 antibody; FADD like ICE antibody; FLICE antibody; ICE like apoptotic protease 5 antibody; MACH antibody; MCH5 antibody
-
Isotype
Mouse IgG2b
-
Preparation
This antibody was obtained by immunization of Caspase 8/p18 recombinant protein (Accession Number: BC028223). Purification method: Protein A purified.
-
Clonality
Monoclonal
-
Formulation
PBS with 0.02% sodium azide and 50% glycerol pH 7.3.
-
Storage instructions
Store at -20℃. DO NOT ALIQUOT
-
Applications
Recommended Dilution:
WB: 1:500-1:5000
IP: 1:200-1:2000
IHC: 1:20-1:200
-
Validations

WB result of CASP8 with normal and apotosis Hela cell. P18 can be get in the apotosis cell. 60kd,50kd and 45kd bands are some isoforms of precursor CASP8.

Immunohistochemistry of paraffin-embedded human liver slide using Catalog No:107033(CASP8 Antibody) at dilution of 1:50
Immunohistochemistry of paraffin-embedded human liver slide using Catalog No:107033(CASP8 Antibody) at dilution of 1:50

IP Result of anti-Caspase 8 (IP:Catalog No:107033, 5ug; Detection:Catalog No:107033 1:500) with HepG2 cells lysate 2400ug.
-
Background
Caspase 8, also named as MCH5, MACH, FLICE, and CAP4, belongs to the peptidase C14A family. It may participate in the GZMB apoptotic pathways and functions as an upstream regulator in a-bisabolol-induced apoptosis. Caspase 8 catalyzes an essential intermediate step in the ubiquitination and proteasome-mediated degradation of IRF3(PMID:21816816 ). It may control diabetic embryopathy-associated apoptosis via Caspase 8 is expressed as nine isoforms by alternative splicing with the molecular mass from 26 kDa to 62 kDa.
-
References
- Shan X, Tian LL, Zhang YM, Wang XQ, Yan Q, Liu JW. Ginsenoside Rg3 suppresses FUT4 expression through inhibiting NF-κB/p65 signaling pathway to promote melanoma cell death. International journal of oncology. 47(2):701-9. 2015.
- Khan MN, Wang B, Wei J. CXCR1/2 antagonism with CXCL8/Interleukin-8 analogue CXCL8(3-72)K11R/G31P restricts lung cancer growth by inhibiting tumor cell proliferation and suppressing angiogenesis. Oncotarget. 6(25):21315-27. 2015.
Related Products / Services
Please note: All products are "FOR RESEARCH USE ONLY AND ARE NOT INTENDED FOR DIAGNOSTIC OR THERAPEUTIC USE"
